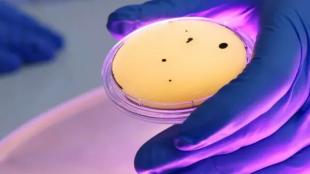

технології
12:32 30.06.2022
Суспільство
Новини
Тисячі вірусів, які вчені нещодавно виявили у Світовому океані, мають величезний вплив на екосистеми. Вони частково «перепрограмовують» носії, яких вони інфікують. До такого висновку прийшла група вчених з різних інститутів, повідомляє видання Live Science.
Нове...
10:45 29.06.2022
Суспільство
Новини
У ході досліджень, проведених дослідниками з Медичної школи Вашингтонського університету в Сент-Луїсі (США) та колегами з інших закладів, винайдена технологія діагностування, яка може швидко та надійно визначити наявність вірусу Ебола у зразках крові. Рання діагностика...
12:14 26.06.2022
Суспільство
Новини
У клінічному дослідженні у пацієнтів з раком прямої кишки зникли пухлини після того, як вони прийняли експериментальний препарат під назвою достарлімаб, повідомляє видання Live Science.
Поки що рано говорити про те, чи підходять ліки людям з різними типами раку...
17:39 19.06.2022
Суспільство
Новини
Дослідники з Токійського університету Кота Мачіда та Юя Сакаї розробили технологію, яка перетворює харчові відходи у цемент для будівництва, повідомляє видання The Arkansas Democrat-Gazette.
Це перший у світі метод виробництва цементу повністю з харчових відходів....
11:02 01.06.2022
Суспільство
Новини
Вчені та інженери Техаського університету в Остіні знайшли рішення проблеми дефіциту води для людей, які проживають в засушливих місцях нашої планети, повідомляє видання Technology Networks.
Команда розробила недорогу гелеву плівку з великої кількості матеріалів,...